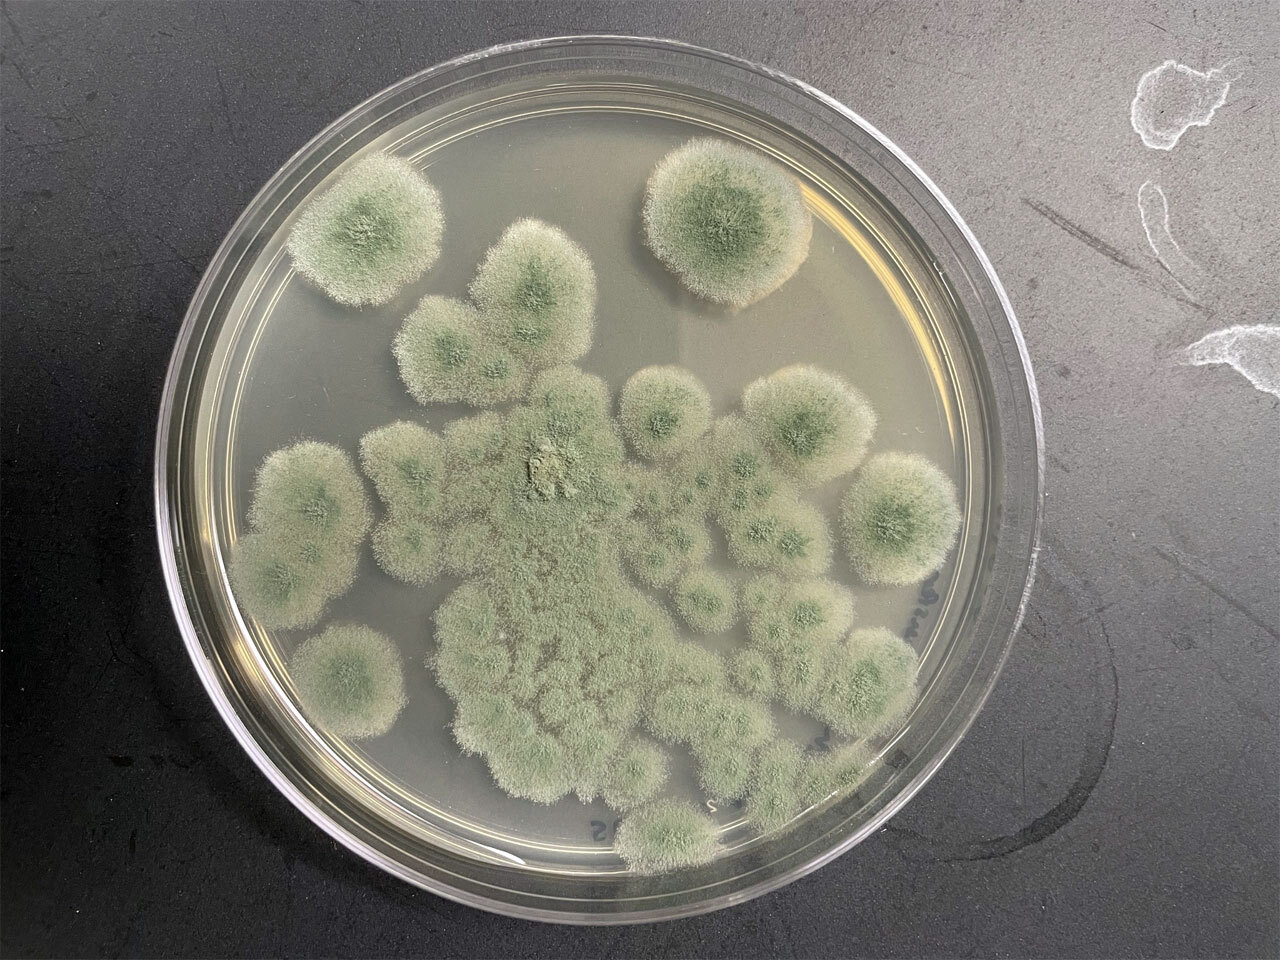
Плесень, способная выжить на Марсе

В чистых помещениях НАСА нашли плесень, способную выжить на Марсе

Есть ли жизнь на Марсе? Ученые склоняются к тому, что вполне могла быть в далеком прошлом, когда планета была теплой и влажной. Новое открытие стало еще одним аргументом: оказалось, жизнь там и сейчас возможна — если человечество ее своими неосторожными действиями занесет.
Во всяком случае, достаточно простая. Опыты над плесневым грибом Aspergillus calidoustus, результаты которых опубликованы в Applied and Environmental Microbiology, показали, что его споры могут выдерживать самые суровые условия. И если НАСА не изменит свои протоколы очистки, изучающие Марс космические аппараты могут его этим грибком заразить.
«На самом деле речь идет об ответственном освоении космоса. Исследуя Вселенную, мы должны быть уверены, что отправляем аппараты, не занося с собой никаких живучих земных микробов», — говорит биомедик Атул М. Чандер из Университета Миссисипи, ведущий автор статьи.
В своей работе НАСА руководствуется, помимо прочего, протоколом планетарной защиты. Его цель — не допустить, чтобы земная биология загрязнила небесные тела (и наоборот). Соблюдение нормативов контролирует группа биотехнологии и планетарной защиты Лаборатории реактивного движения (BPPG).
Предыдущие исследования выявляли различные бактерии и грибы на поверхностях чистых помещений НАСА, включая помещения с ультрафильтрацией, где строят и испытывают космические корабли. Там сотрудники, занятые в сборке, носят комбинезоны с полной изоляцией и маски, но современные методы дезинфекции направлены главным образом на уничтожение бактерий, а не грибов.
Грязный пол чистых комнат
В ходе исследования ученые изучили 27 штаммов грибов, собранных на полу чистых комнат, использовавшихся в миссии «Марс-2020», которая доставила на Марс ровер Perseverance, а также два контрольных микроба, славящихся своей устойчивостью к радиации. Большинство образцов, выдержавших предварительную проверку ультрафиолетом, более интенсивных испытаний не перенесли, но A. calidoustus, взятый из сборочного центра во Флориде, выжил.
Споры A. calidoustus подвергли шестимесячному хроническому нейтронному излучению, имитирующему космический перелет, и уцелела почти половина из них. Их нагревали сухим жаром до 125 °C (температура, обычно используемая для стерилизации компонентов космических аппаратов), и споры пережили даже Bacillus pumilus — вид, который НАСА часто использует в роли эталона.
Кроме того, устойчивость спор оценили в суровых условиях, имитирующих обстановку на самом Марсе: 24 часа экстремального УФ-излучения, низкое атмосферное давление и средняя температура −60 °C. Для верности вдобавок ко всему их поместили в аналог агрессивной марсианской почвы.
«Мы пытаемся найти предел прочности этих микробов, — объясняет Чандер. — Такая степень устойчивости — мягко говоря, необычна».
Атмосфера вызвала точечную эрозию и образование рубцов на поверхности микробов, но не привела к их гибели, а марсианский реголит, похоже, оказал буферное действие, помогая спорам пережить низкое давление. К полному уничтожению их привело только одновременное сочетание экстремальной радиации и охлаждения.
Что дальше
Авторы отказались комментировать, мог ли A. calidoustus уже попасть на Марс, пояснив, что это выходит за рамки исследования. Однако они отметили, что их эксперименты могут быть полезны в таких отраслях, как фармацевтика, медицина и производство продуктов питания, поскольку похожие грибы способны выживать при пастеризации и тепловой обработке аналогичным образом.
«Знание, что какой-то организм может выжить при 125 °C плюс радиация, делает его модельным для разработки новых стандартов стерилизации», — резюмирует Чандер.
А пока исследователи сосредоточены на том, чтобы не допустить попадания земных организмов в космос. Страшно даже представить всеобщее разочарование, если вдруг на Марсе откроют жизнь — а она окажется безбилетным пассажиром из Флориды.

































